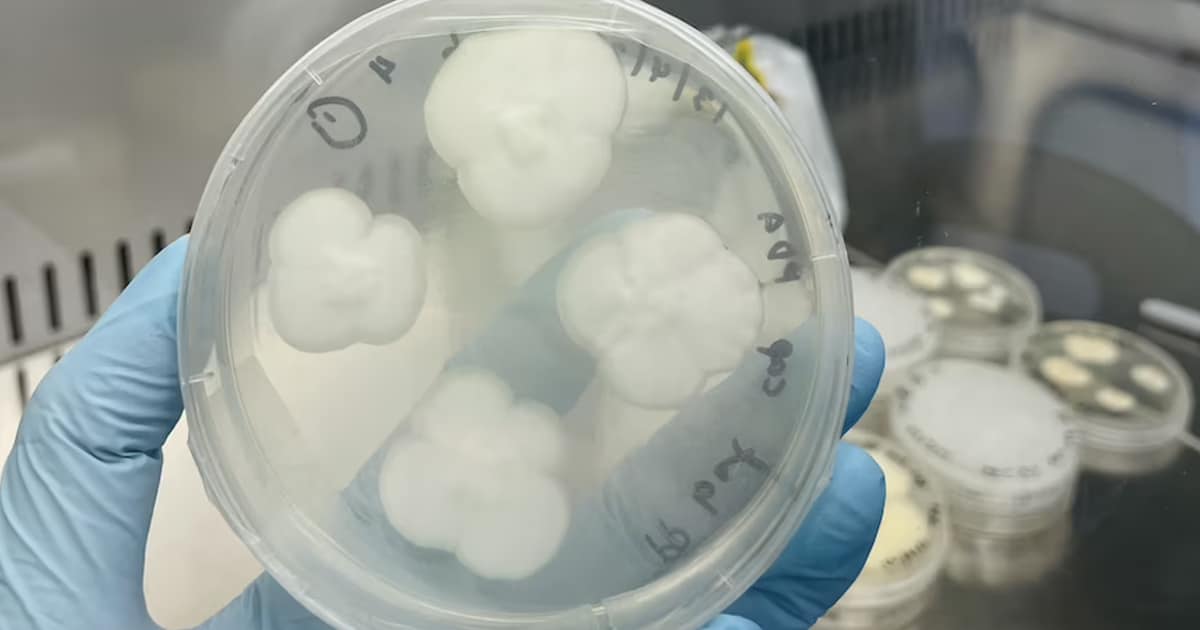

[ad_1]

This fungus breaks down polypropylene plastic. (Picture: Amira Farzana Samat/College of Sydney)
Our earth has a plastic dilemma. Accrued squander and continual creation have resulted in mounds of trash all around the globe and bobbing in our oceans. Recycling is a very good phase, but it is limited by the technology’s availability and the situation of the plastic in dilemma. With 175 million tonnes (192.9 million tons) of plastic ending up in landfills or as litter for every year of the 400 million tonnes (440 million tons) developed around the world, it is a large issue that has stumped society for a long time. As researchers endeavor to generate methods to crack down this non-biodegradable trash, a group of researchers at the University of Sydney found out two common kinds of yard fungi can breakdown polypropylene completely in 140 days.
In a study posted in NPJ Materials Degradation, the scientists specific the final results of making use of Aspergillus terreus and Engyodontium album on polypropylene plastic. The two species of fungi are widespread forms of mould. The workforce picked samples of polypropylene, a plastic that will make up to-go containers, plastic movie, and other delicate plastics. It is not often recycled and, like other plastics, requires many years to degrade. The plastics had been heated and treated with each UV radiation and Fenton’s chemical (a reagent).
Upcoming, the plastics have been “fed” to the fungi and authorized to incubate for 90 times. Just after 90 days, the plastic was 27% degraded. Right after 140 days, it was totally degraded. Professor Ali Abbas, a paper writer, mentioned to ABC Internet Australia, “It’s the greatest degradation amount reported in the literature that we know in the world.” Inside five many years, the staff hopes the fungi can be breaking down landfills around the country. “It is scaling up which is really a great deal identical to any sort of fermentation system,” Abbas said. “That engineering presently exists for all those processes and we’re ready to now borrow that understanding from chemical process engineering and carry it into this certain approach in this article.”
Industrial programs could be even a lot quicker with funding and political will. The mould alternative could be pivotal for isolated locations which produce waste but deficiency infrastructure or place to house the squander. This likely alternative adds to others such as plastic-feeding on worms to attack our squander. Having said that, the earth also needs to cut down its plastic use, even if comprehensive degradation results in being common. Plastic generation, as properly as recycling, make carbon in significant quantities. Degrading by way of mildew will also release carbon. Even though this kind of options are notably important for current squander, the initially R in “Reduce, Reuse, Recycle” is still the most important.
Scientists have employed common backyard fungi to wipe out some of the hardest plastics.


The fungi sets to function. (Image: University of Sydney)
The molds can demolish polypropylene when activated by warmth.


College of Sydney scientists Ali Abbas (left) and Amira Farzana Samat (right). (Photograph: University of Sydney)
As accumulating plastics are a vital environmental challenge, the lookup for alternatives is critical.
h/t: [ABC.Net.Au]
Connected Posts:
Giant “Faucet” Spewing Solitary-Use Plastic Urges Us To Reconsider Our Plastic Use
What Is an Ecobrick? Learn About How You Can Construct Factors Using Your Plastic Trash
Ocean Cleanup Has Eradicated More than 220 Tons of Plastic Out of the Pacific Ocean
Student Types 3D-Printed Robotic Fish That Filters Microplastics From Water
[ad_2]
Resource website link






Leave a Reply